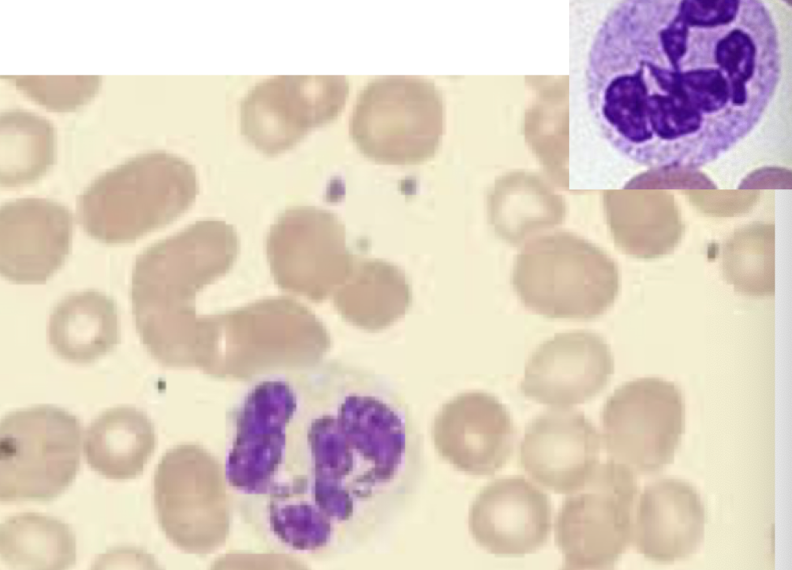
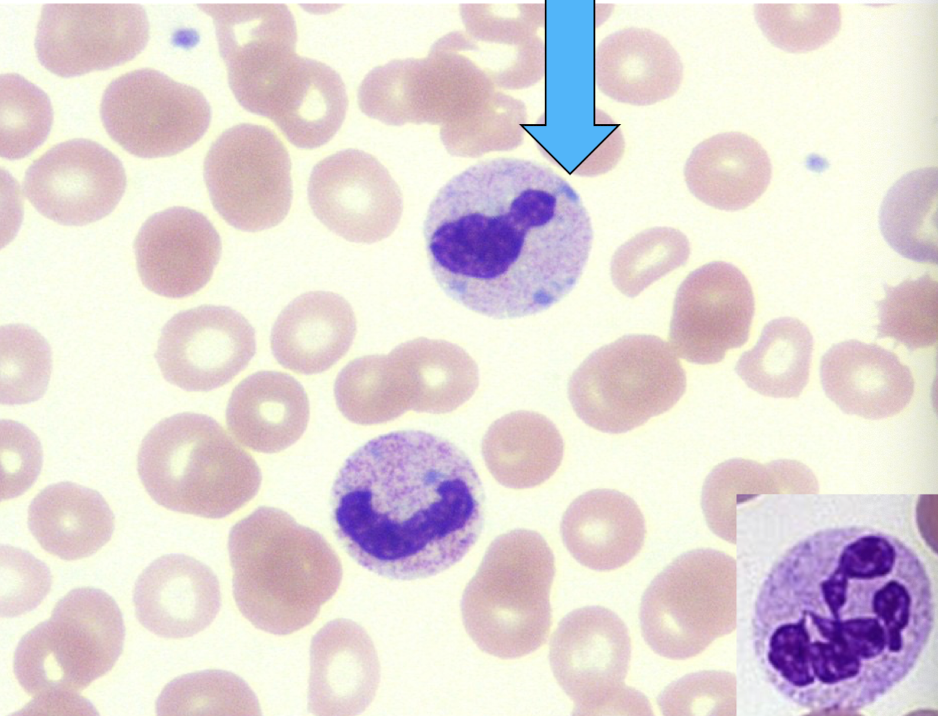
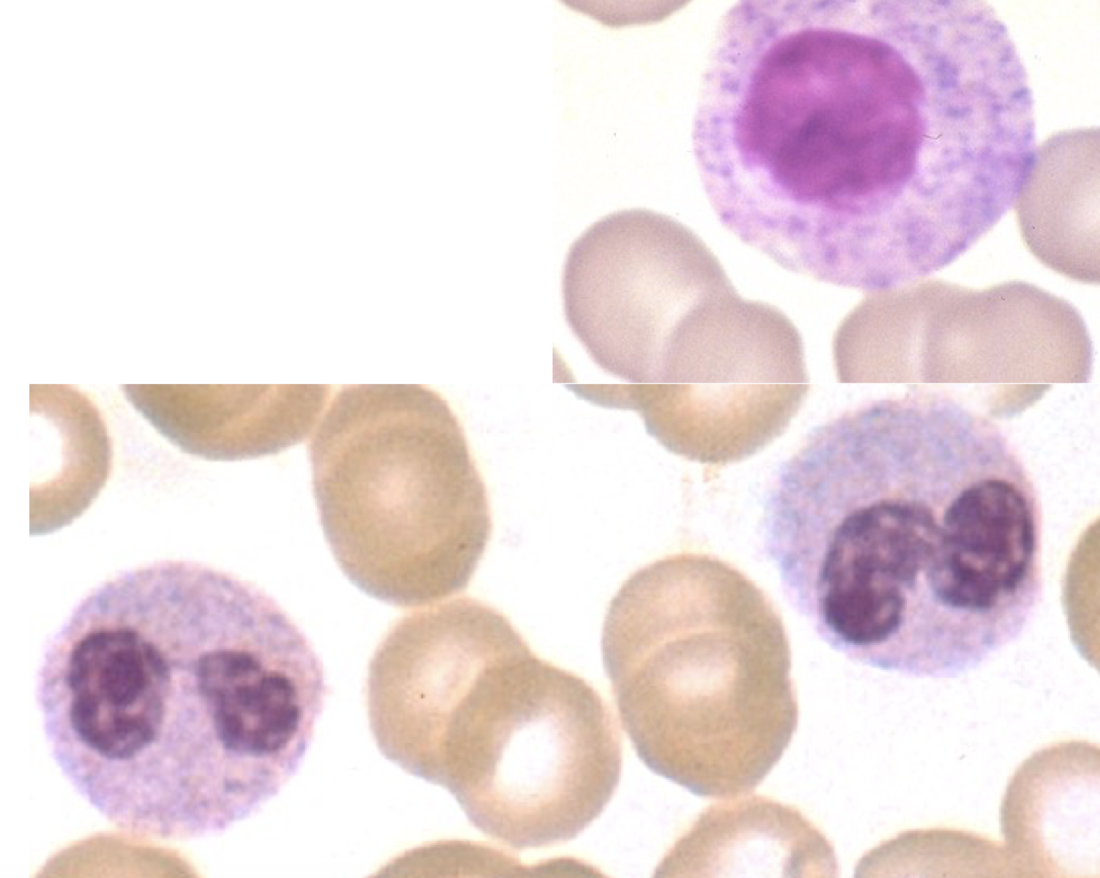
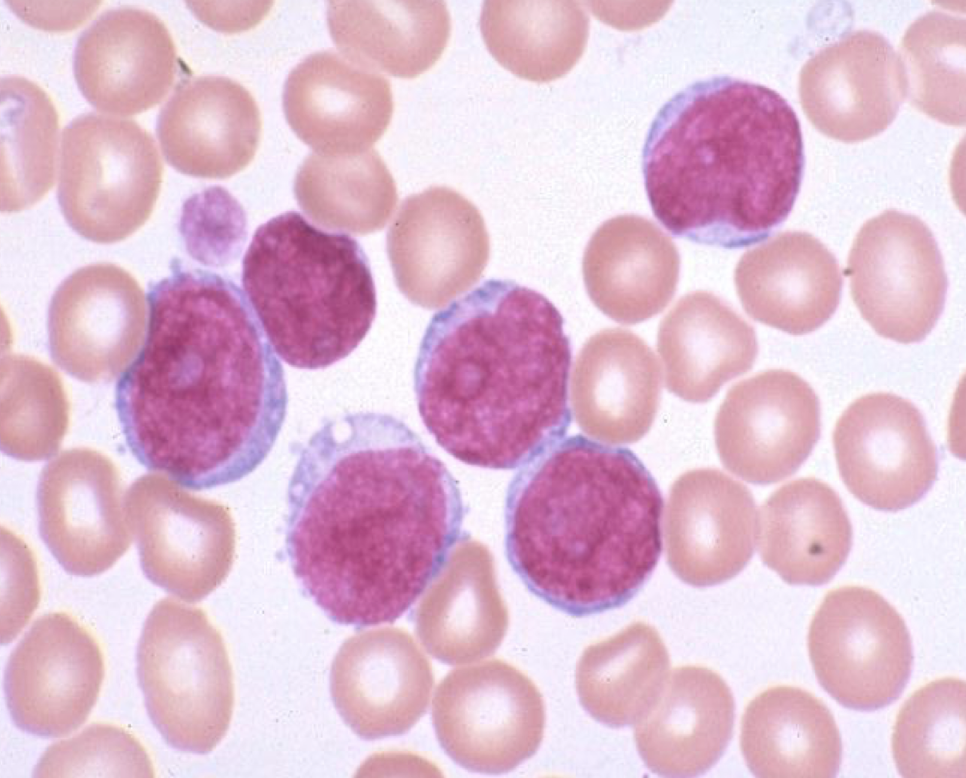
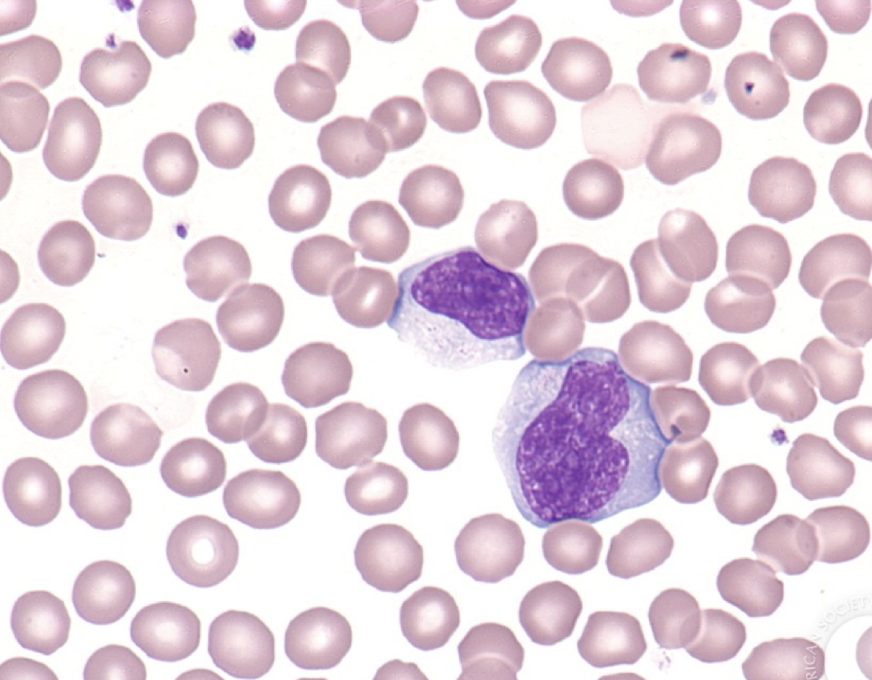
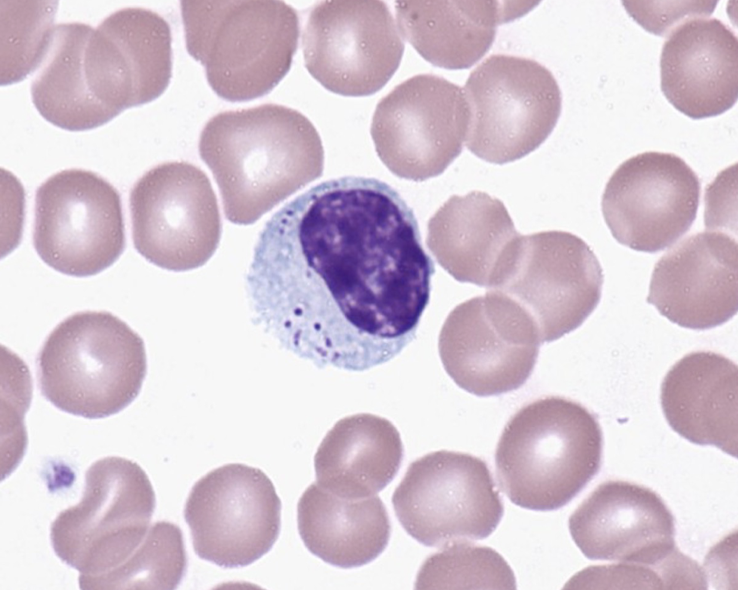

L shift
immature granulocytes in the blood

pregnancy
infection
myelofibrosis

immature to mature (L to R)
increased granulation (toxic granulation)

bacterial infection
tissue damage
“toxic granulation” but present in all leukocytes (not just granulocytes)
inherited anomaly

Alder-Reilly Anomaly
normal top R
reduced granulation in neutrophil cytoplasm (hypogranulation)
myelodysplastic syndrome
vacuoles in the cytoplasm of granulocytes (toxic vacuoles)

infection
toxic effect of alcohol
small pale blue cytoplasmic inclusions
(Dohle bodies)
infective and inflammatory states
burns
chemo
AD disorder
giant platelets
bright blue Dohle like inclusions in WBC
moderate thrombocytopenia

May-Hegglin Anomaly
increased neutrophils with 6 segments or more
(hypersegmented neutrophils)

megaloblastic anemia
mono or bilobed neutrophils w/ condensed chromatin
(hyposegmentation)
Pelger-Huet anomaly
found in myelodysplastic syndrome
various microorganisms in vacuoles in cytoplasm of neutrophils
(phagocytosed organisms)

bacterial, fungal, protozoal infections
primitive, immature cells seen in acute leukemia and myelodysplastic syndrome
circulating blasts
rods in cytoplasm seen in acute myeloid leukemia and myelodysplastic syndrome
have MPO in them

Auer rods
pleomorphic, large w/ abundant basophilic cytoplasm
found in viral infections, bacterial and protozoal; drug rxns, stress, autoimmune
variant (atypical) lymphocytes
small eosinophilic granules in the cytoplasm of large lymphocytes
found in viral infections, RA, lymphocytic leukemia
large granular lymphocytosis

common reactive changes
granulocytes, monocytes, lymphocytes
WBCs
increased in response to acute body stress
can phagocytose and kill microorganisms
most numerous WBC
2-3 segments usually

neutrophils

lymphocytes

transformed into histiocytes upon entrance of the tissues
APCs

monocytes
specialized in killing parasitesand mediate allergic responses

eosinophils
have IgE receptors and mediate hypersensitivity rxns
similar but distinctive from mast cells
least common type of WBC

basophils
-cytosis
-philia
-emia
increased numbers
-penia
decreased numbers



